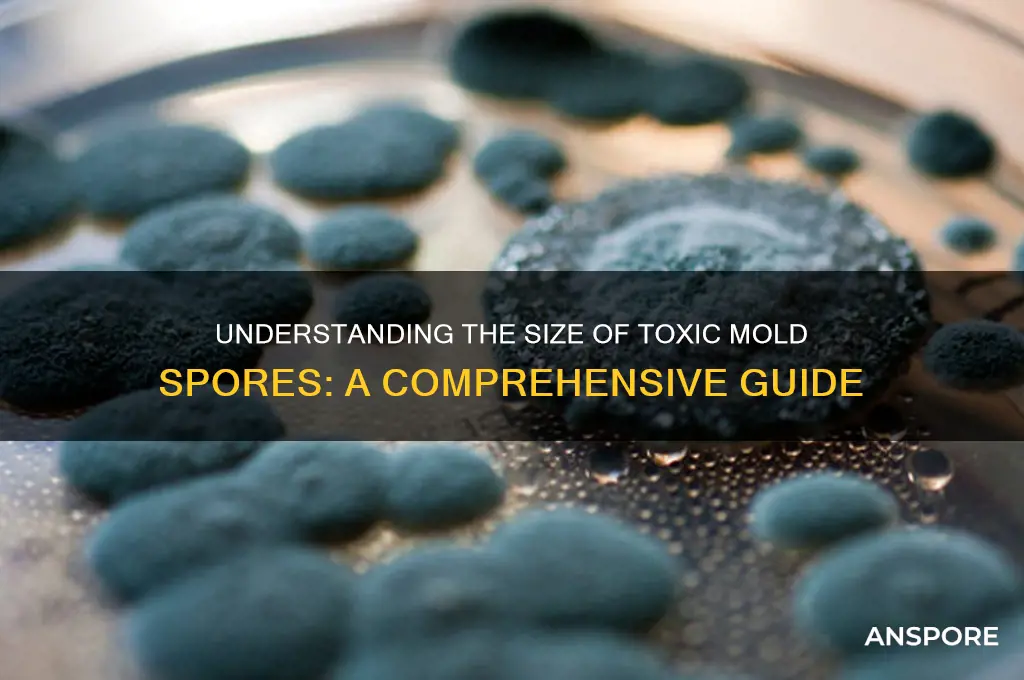
how big are tach mold spores

Tach mold spores, often associated with various types of fungi, are microscopic in size, typically ranging from 2 to 100 micrometers in diameter, making them invisible to the naked eye. Their small size allows them to easily disperse through the air, water, or on surfaces, contributing to their widespread presence in both indoor and outdoor environments. Understanding the size of these spores is crucial, as it influences their ability to infiltrate respiratory systems, potentially causing health issues, and their role in mold proliferation. Factors such as humidity, temperature, and ventilation can affect spore size and distribution, making them a significant consideration in mold prevention and remediation efforts.
Explore related products
$13.48 $14.13
What You'll Learn
- Tach Mold Spore Size Range: Typical size of tach mold spores in microns
- Comparison to Other Spores: How tach mold spores compare in size to common molds
- Measurement Techniques: Methods used to measure the size of tach mold spores
- Size Variability Factors: Environmental and genetic factors affecting spore size variation
- Health Impact by Size: How spore size influences their potential health risks

Tach Mold Spore Size Range: Typical size of tach mold spores in microns
Tach mold spores, like many fungal spores, are microscopic entities that defy detection by the naked eye. Their size typically ranges between 3 to 10 microns in diameter, though this can vary slightly depending on the species and environmental conditions. To put this into perspective, a human hair averages about 75 microns in width, making these spores roughly 7 to 25 times smaller. This minuscule size allows them to remain suspended in air for extended periods, facilitating their spread and increasing the likelihood of inhalation.
Understanding the size range of tach mold spores is crucial for effective detection and remediation. Spores in the 3 to 5 micron range are particularly problematic because they can penetrate deep into the respiratory system, potentially causing allergic reactions or exacerbating respiratory conditions like asthma. Larger spores, around 8 to 10 microns, are more likely to be trapped in the upper respiratory tract but can still pose health risks in high concentrations. Air quality monitors and HEPA filters are designed to capture particles as small as 0.3 microns, making them effective tools for reducing spore levels indoors.
Comparatively, tach mold spores are smaller than pollen grains, which typically measure 10 to 100 microns, but larger than viruses, which are often less than 1 micron. This size places them in a category of airborne particles that are easily inhaled but not as easily filtered by natural mechanisms like nasal hairs. For individuals with mold sensitivities, knowing this size range can inform preventive measures, such as using respirators with N95 ratings, which filter out particles as small as 0.3 microns.
Practical tips for managing tach mold spores include maintaining indoor humidity below 50%, as spores thrive in moist environments. Regularly cleaning air ducts and using dehumidifiers in damp areas can also reduce spore proliferation. For those conducting mold inspections, air sampling devices with filters capable of capturing particles in the 3 to 10 micron range are essential for accurate detection. While their size makes them invisible, their impact on health and indoor air quality is tangible, underscoring the importance of proactive monitoring and control.
Ozone Machines vs. Mold Spores: Effective Solution or Myth?
You may want to see also

Comparison to Other Spores: How tach mold spores compare in size to common molds
Tach mold spores, often associated with certain types of fungi, are microscopic entities that play a significant role in mold propagation. To understand their size, it’s essential to compare them to spores of common molds like *Aspergillus*, *Penicillium*, and *Cladosporium*. Tach mold spores typically measure between 3 to 5 micrometers (μm) in diameter, placing them within the range of many household molds. For context, *Aspergillus* spores are slightly smaller, averaging 2 to 3 μm, while *Cladosporium* spores are larger, ranging from 5 to 10 μm. This comparison highlights that tach mold spores are mid-sized, making them neither the smallest nor the largest among common mold spores.
Analyzing the implications of spore size reveals its impact on dispersal and health risks. Smaller spores, like those of *Aspergillus*, can remain airborne longer and penetrate deeper into the respiratory system, increasing the risk of allergic reactions or infections. Tach mold spores, being moderately sized, strike a balance—they can travel through the air but are less likely to reach the deepest lung tissues compared to their smaller counterparts. This makes them a moderate concern for indoor air quality, particularly in environments with poor ventilation.
From a practical standpoint, understanding spore size helps in selecting appropriate filtration systems. HEPA filters, which capture particles as small as 0.3 μm, are effective against tach mold spores and most common molds. However, for smaller spores like *Aspergillus*, additional measures such as UV-C light or activated carbon filters may be necessary to reduce airborne concentrations. Homeowners should prioritize regular HVAC maintenance and humidity control to minimize mold growth, regardless of spore size.
A persuasive argument for monitoring tach mold spores lies in their potential health effects. While not as notorious as *Stachybotrys* (black mold), tach mold spores can still trigger allergies, asthma, and respiratory issues, especially in sensitive individuals. Comparing their size to other spores underscores the need for proactive mold management. For instance, using dehumidifiers to keep indoor humidity below 50% and promptly addressing water leaks can prevent spore proliferation. Ignoring these measures risks turning a moderate-sized spore into a significant health hazard.
In conclusion, tach mold spores occupy a middle ground in size compared to common molds, but their impact on health and indoor air quality should not be underestimated. By understanding their dimensions relative to other spores, individuals can implement targeted strategies to mitigate risks. Whether through filtration, humidity control, or professional mold remediation, addressing tach mold spores is a critical step in maintaining a healthy living environment.
Spore Cute and Creepy Mac Release: Did It Happen?
You may want to see also

Measurement Techniques: Methods used to measure the size of tach mold spores
Tach mold spores, like other fungal spores, are microscopic entities, typically ranging from 2 to 20 micrometers (μm) in size. Accurately measuring their dimensions is crucial for identification, risk assessment, and remediation efforts. Several specialized techniques are employed to achieve this precision, each with its own advantages and limitations.
Microscopy: The Visual Approach
The most common method for measuring tach mold spore size is light microscopy. This technique involves placing a spore sample on a slide, staining it for enhanced visibility, and examining it under a microscope. Calibrated eyepiece micrometers or software-based measurement tools allow for direct measurement of spore length, width, and thickness. While relatively inexpensive and accessible, light microscopy has limitations. Resolution is dependent on the microscope's magnification and the quality of the lens, and individual spore orientation can affect measurements.
Flow Cytometry: Sorting and Sizing
Flow cytometry offers a more automated and high-throughput approach. This technique suspends spores in a fluid stream, passing them through a laser beam. Light scattering patterns are analyzed to determine spore size and complexity. Flow cytometry excels at rapidly analyzing large numbers of spores, providing statistical data on size distribution. However, it may struggle with distinguishing between spores and other particulate matter in a sample, requiring careful sample preparation.
Image Analysis: Digital Precision
Advances in digital imaging and software have led to sophisticated image analysis techniques. High-resolution images of spore samples are captured using microscopes or specialized cameras. Software algorithms then analyze these images, identifying individual spores and measuring their dimensions with high precision. This method offers excellent accuracy and repeatability, but relies on the quality of the initial image and the robustness of the analysis software.
Atomic Force Microscopy: Nanometer-Scale Resolution
For the most precise measurements, atomic force microscopy (AFM) can be employed. AFM uses a tiny cantilever with a sharp tip to scan the surface of a spore, creating a topographic map with nanometer-scale resolution. This technique provides detailed information about spore surface features and can measure individual spores with exceptional accuracy. However, AFM is a time-consuming and specialized technique, requiring expensive equipment and skilled operators.
Choosing the Right Technique
The most suitable method for measuring tach mold spore size depends on the specific application. For routine identification and general size estimation, light microscopy is often sufficient. Flow cytometry is ideal for rapid analysis of large samples, while image analysis provides high precision for detailed studies. AFM offers unparalleled resolution for research purposes. By understanding the strengths and limitations of each technique, researchers and professionals can select the most appropriate method for accurately determining the size of tach mold spores.
Does Spore Take 2 Turns? Debunking the Myth in Gameplay
You may want to see also
Explore related products

Size Variability Factors: Environmental and genetic factors affecting spore size variation
Tach mold spores, like those of many fungi, exhibit size variability influenced by a complex interplay of environmental and genetic factors. Understanding these factors is crucial for fields such as mycology, agriculture, and indoor air quality management. Spore size directly impacts dispersal efficiency, germination success, and allergenic potential, making its variability a significant area of study.
Environmental Factors: The External Shapers of Spore Size
Temperature, humidity, nutrient availability, and light exposure are primary environmental determinants of spore size. For instance, studies show that *Aspergillus* spores, a common tach mold genus, tend to be larger when grown in high-humidity conditions (above 70% relative humidity) compared to drier environments. Similarly, nutrient-rich substrates, such as those with elevated nitrogen levels (e.g., 10–20 mM nitrate), often produce larger spores due to increased metabolic resources. Conversely, stress conditions like low water availability or extreme temperatures (below 15°C or above 35°C) can result in smaller, more resilient spores. Practical tip: To minimize large spore production in indoor environments, maintain humidity below 60% and ensure proper ventilation to reduce nutrient accumulation on surfaces.
Genetic Factors: The Intrinsic Blueprint of Spore Development
Genetic variability within tach mold species plays a pivotal role in spore size. For example, mutations in genes controlling cell wall synthesis or sporulation pathways can lead to size discrepancies. A study on *Penicillium* strains revealed that a single nucleotide polymorphism (SNP) in the *brlA* gene, which regulates spore formation, resulted in spores 20–30% smaller than wild-type counterparts. Additionally, hybridization between different mold species can produce spores with intermediate sizes, highlighting the role of genetic recombination. Takeaway: Genetic analysis of mold strains in a given environment can predict spore size distribution, aiding in targeted control strategies.
Interaction of Environmental and Genetic Factors: A Dynamic Duo
The interplay between environment and genetics often amplifies spore size variability. For instance, a genetically predisposed small-spore strain may produce larger spores when exposed to optimal growth conditions, such as 25°C and ample nutrients. Conversely, a large-spore strain may shrink under stress. This interaction is particularly relevant in indoor settings, where fluctuating conditions (e.g., seasonal humidity changes) can alter spore size profiles. Caution: Relying solely on environmental control without considering genetic diversity may lead to incomplete mold management.
Practical Implications: Tailoring Strategies for Spore Size Variability
Understanding size variability factors allows for more precise interventions. In agriculture, selecting mold strains with specific spore sizes can enhance crop colonization or biocontrol efficacy. For indoor air quality, HEPA filters with pore sizes below 0.3 microns effectively capture most tach mold spores, regardless of size variation. Additionally, monitoring environmental conditions and genetic trends in mold populations can predict spore size shifts, enabling proactive measures. Example: In a study of *Cladosporium* spores, combining humidity control (below 50%) with genetic screening reduced large spore counts by 40% in residential settings.
Addressing tach mold spore size variability requires a dual focus on environmental manipulation and genetic understanding. By integrating these factors, stakeholders can develop targeted strategies to mitigate risks and optimize applications. Whether in research, agriculture, or indoor environments, recognizing the dynamic nature of spore size ensures more effective and sustainable outcomes.
Are C. Diff Spores Everywhere? Uncovering the Hidden Truth
You may want to see also

Health Impact by Size: How spore size influences their potential health risks
Mold spores, including those from *Stachybotrys chartarum* (often referred to as "toxic black mold"), vary in size, typically ranging from 3 to 100 micrometers. This size variation is critical because it directly influences how spores interact with the human body. Smaller spores, under 5 micrometers, can penetrate deep into the respiratory system, reaching the alveoli in the lungs. Larger spores, above 10 micrometers, are more likely to get trapped in the upper respiratory tract or exhaled before causing significant harm. Understanding this size-based behavior is essential for assessing health risks and implementing targeted prevention strategies.
Consider the health implications for vulnerable populations, such as children, the elderly, and individuals with compromised immune systems. For instance, spores smaller than 5 micrometers pose a higher risk to asthmatic children, as they can trigger severe bronchial inflammation and asthma attacks. A study published in *Indoor Air* found that prolonged exposure to small mold spores increased asthma symptoms in children by 30%. In contrast, larger spores may cause milder reactions, such as nasal congestion or sneezing, in healthy adults. Practical tips for reducing exposure include using HEPA filters, which are effective at capturing particles as small as 0.3 micrometers, and maintaining indoor humidity below 50% to inhibit mold growth.
The size of mold spores also dictates their dispersal and persistence in indoor environments. Smaller spores remain airborne longer, increasing the likelihood of inhalation, while larger spores settle more quickly on surfaces. This distinction is crucial for remediation efforts. For example, cleaning settled large spores from surfaces with a damp cloth can reduce exposure, but airborne small spores require air purification systems. A comparative analysis of mold remediation techniques in *Environmental Health Perspectives* highlights that combining HEPA filtration with regular surface cleaning reduces spore counts by up to 70%, significantly lowering health risks.
From a persuasive standpoint, prioritizing spore size in health risk assessments can lead to more effective public health policies. Regulatory bodies should mandate air quality standards that specifically address small spore concentrations in schools, hospitals, and workplaces. For instance, the EPA recommends limiting indoor mold spore counts to below 500 spores per cubic meter, but this threshold should be adjusted based on spore size. Smaller spores warrant stricter limits due to their deeper penetration and higher toxicity potential. Advocacy for size-specific monitoring and mitigation can prevent long-term health issues like chronic respiratory conditions and allergic reactions.
In conclusion, spore size is a critical determinant of health risks associated with mold exposure. Smaller spores pose greater dangers due to their ability to infiltrate the lower respiratory system, while larger spores are less harmful but still require attention. Tailoring prevention and remediation strategies to spore size can significantly reduce health impacts, especially in vulnerable populations. By integrating size-specific data into health guidelines and remediation practices, individuals and policymakers can create safer indoor environments and mitigate the adverse effects of mold exposure.
Understanding the Diverse Methods of Spores Spread in Nature
You may want to see also
Frequently asked questions
Tach mold spores, like most mold spores, are microscopic, typically ranging from 3 to 40 micrometers (μm) in size. They are not visible to the naked eye and require a microscope for detection.
No, tach mold spores are too small to be seen without a microscope. However, mold growth itself can often be visible as discoloration or patches on surfaces.
Tach mold spores are generally similar in size to other common mold spores, ranging from 3 to 40 micrometers. The size can vary slightly depending on the specific mold species, but they are all microscopic.

























